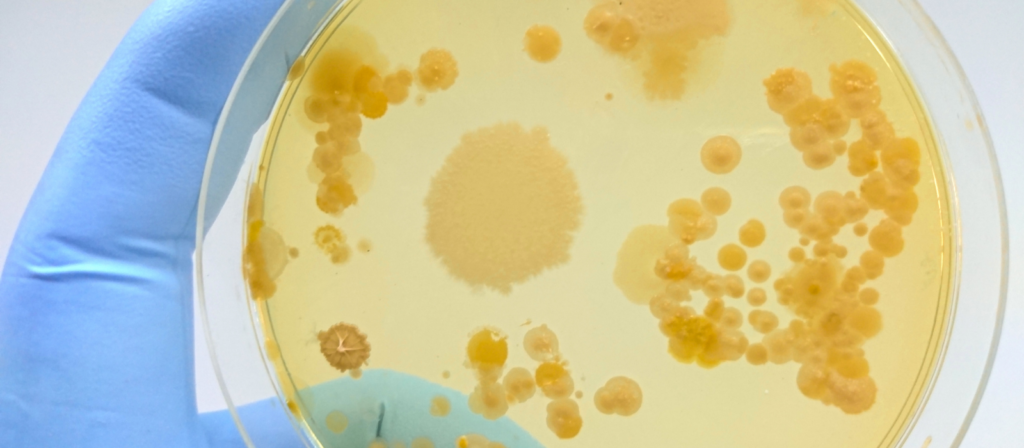

O que é o Ágar Cled? Qual a sua função?
Bem-vindo ao mundo da microbiologia! Você já ouviu falar sobre o ágar Cled ? Este meio de cultura é amplamente utilizado em laboratórios microbiológicos e desempenha um papel fundamental na identificação de bactérias. Se você está estudando microbiologia ou trabalhando nesta área, é essencial ter conhecimento sobre o ágar cled e sua importância.
O meio de cultura chamado de Ágar Cled ou meio Cystine-Lactose-Electrolyte-Deficiente (CLED Ágar ), descrito pela primeira vez por Sandys e posteriormente modificado por Mackey e Sandys, é geralmente usado para bacteriologia urinária de rotina diagnóstica como um meio não seletivo capaz de suportar o crescimento da maioria dos patógenos urinários.
O que é o Ágar Cled?
O Ágar Cled é um meio de cultura diferencial utilizado para o isolamento e enumeração de bactérias da urina. O meio ágar cled suporta o crescimento de todos os patógenos potenciais urinários e fornece morfologia de colônia distinta. Apoia o crescimento de patógenos e contaminantes urinários e dá uma boa diferenciação colonial sem a disseminação de espécies de Proteus devido à sua falta de eletrólitos.
O Ágar CLED (Cystine Lactose Electrolyte Deficient Agar) é um meio de cultura usado em microbiologia para o cultivo e isolamento de bactérias, especialmente aquelas encontradas no trato urinário. O meio é formulado para evitar a multiplicação de Proteus spp., uma bactéria que pode distorcer os resultados ao espalhar-se rapidamente sobre a superfície do meio.
As principais características do Ágar CLED são:
- Ausência de eletrólitos: Isso previne a formação de swarming (espalhamento rápido) de Proteus spp.
- Presença de lactose: Serve como um indicador. Bactérias que fermentam lactose produzem colônias amarelas, enquanto aquelas que não fermentam permanecem incolores ou azuis.
- Cistina: Um aminoácido que serve como nutriente para o crescimento bacteriano.
Esse meio é bastante utilizado em laboratórios de microbiologia, particularmente em análises relacionadas a infecções do trato urinário, pois permite a diferenciação de uma variedade de bactérias urinárias com base na sua capacidade de fermentar lactose.
Composição do Ágar Cled
A composição do Ágar Cled (Cystine Lactose Electrolyte Deficient Agar) é cuidadosamente balanceada para fornecer um ambiente adequado para o cultivo de bactérias urinárias, ao mesmo tempo que inibe certos fenômenos como o swarming de Proteus. Sua composição típica inclui:
- Lactose: Serve como a fonte de carboidrato fermentável. Bactérias que fermentam lactose produzem colônias amarelas, enquanto as não fermentadoras formam colônias azuis ou incolores.
- Cistina: Um aminoácido que enriquece o meio e suporta o crescimento de bactérias.
- Agar: Um agente solidificante que proporciona a consistência semi-sólida do meio.
- Azul de Bromotimol: Um indicador de pH que muda de cor em resposta à acidificação do meio devido à fermentação da lactose.
- Peptona: Uma mistura de proteínas e aminoácidos que fornece nutrientes essenciais para o crescimento bacteriano.
- Eletrólitos em baixa concentração: O meio é formulado com baixos níveis de eletrólitos (daí o nome “Electrolyte Deficient”) para prevenir o swarming de Proteus.
- Água: Usada para dissolver e misturar os componentes.
Esta formulação específica permite o crescimento de uma ampla gama de bactérias urinárias e facilita a diferenciação entre espécies fermentadoras e não fermentadoras de lactose. Além disso, a baixa concentração de eletrólitos ajuda a inibir o swarming de certas bactérias, tornando o Ágar CLED um meio ideal para urinoculturas.
A importância do ágar cled para microbiologia
O ágar Cled (cistina, lactose e eletrólitos desidratados) é uma das ferramentas mais importantes da microbiologia clínica. Ele foi desenvolvido para distinguir entre bactérias coliformes e não-coliformes em amostras de urina.
A importância do ágar Cled reside na sua capacidade de inibir o crescimento excessivo de espécies gram-positivas, como Estreptococos e Staphylococcus, que são comuns na flora normal da urina. Isso permite que as bactérias coliformes se desenvolvam melhor no meio.
Essa distinção é importante porque as bactérias coliformes indicam a presença de contaminação fecal na urina, o que pode ser um sinal precoce de infecções graves do trato urinário ou outras doenças relacionadas ao sistema excretor. A detecção precoce dessas infecções pode salvar vidas.
Vantagens do uso do ágar cled
O ágar Cled é um meio de cultura amplamente utilizado na microbiologia. Embora seja uma escolha popular para o isolamento e identificação de bactérias, existem algumas vantagens e desvantagens no seu uso.
O Ágar CLED (Cystine Lactose Electrolyte Deficient Agar) oferece várias vantagens no cultivo de bactérias, especialmente para análises relacionadas ao trato urinário. Algumas dessas vantagens incluem:
- Inibição do Swarming de Proteus: Uma das principais vantagens do Ágar CLED é sua capacidade de inibir o swarming (espalhamento rápido) de bactérias do gênero Proteus. Isso é importante porque o swarming pode interferir na identificação de outras bactérias presentes na amostra.
- Diferenciação de Bactérias Fermentadoras de Lactose: O meio permite a identificação fácil de bactérias que fermentam lactose, que formam colônias amarelas, em contraste com aquelas que não fermentam lactose, que formam colônias azuis ou incolores.
- Adequado para Urinoculturas: O Ágar CLED é particularmente útil em urinoculturas, pois permite o crescimento de uma ampla gama de patógenos urinários e fornece um bom isolamento de colônias individuais.
- Baixa Toxicidade: O meio é menos tóxico para as bactérias patogênicas comparado a outros meios, o que permite o crescimento e isolamento eficaz de uma variedade de organismos.
- Boa Estabilidade e Durabilidade: O Ágar CLED é estável e tem uma longa vida útil, o que o torna conveniente para uso em laboratórios com menor frequência de preparo de meios frescos.
- Simplicidade e Custo-Efetivo: Comparado a outros meios de cultura especializados, o Ágar CLED é relativamente simples de preparar e mais econômico.
Estas vantagens fazem do Ágar CLED um meio de cultura valioso e frequentemente utilizado em laboratórios de microbiologia, particularmente para análise de amostras de urina.
Como o ágar cled funciona?
O Ágar CLED (Cystine Lactose Electrolyte Deficient Agar) funciona como um meio de cultura seletivo e diferencial, utilizado principalmente para isolar e identificar bactérias do trato urinário. Aqui está como ele funciona:
- Crescimento de Bactérias: O Ágar CLED suporta o crescimento de uma ampla variedade de bactérias urinárias, fornecendo nutrientes essenciais como peptona e cistina. A ausência de sais biliares e a baixa concentração de eletrólitos ajudam a evitar a inibição de bactérias sensíveis.
- Inibição do Swarming de Proteus: Uma das principais funções do Ágar CLED é inibir o swarming (espalhamento rápido sobre a superfície do meio) de bactérias do gênero Proteus. Isso é alcançado através da redução dos eletrólitos no meio. O swarming do Proteus pode obscurecer outras colônias bacterianas, dificultando a identificação e isolamento de outras bactérias presentes na amostra.
- Diferenciação Baseada na Fermentação da Lactose: A lactose é o carboidrato fermentável no meio. Bactérias que fermentam lactose, como Escherichia coli, produzem ácido como produto da fermentação. Este ácido causa uma mudança no indicador de pH (azul de bromotimol) presente no meio, levando à formação de colônias amarelas. Por outro lado, bactérias que não fermentam lactose, como Pseudomonas aeruginosa, não produzem essa mudança, resultando em colônias azuis ou incolores.
- Observação de Características das Colônias: A observação das características das colônias (como cor, tamanho, forma) que crescem no Ágar CLED ajuda na identificação preliminar das bactérias presentes na amostra.
- Cultivo a Temperatura Adequada: Normalmente, as placas de Ágar CLED são incubadas a uma temperatura apropriada (geralmente 35-37°C) para promover o crescimento bacteriano.
O Ágar CLED é particularmente útil em laboratórios de microbiologia para análises de urina, onde é necessário distinguir entre diferentes tipos de bactérias, especialmente em casos de infecções do trato urinário. Ele fornece um equilíbrio entre permitir o crescimento de um amplo espectro de bactérias e ao mesmo tempo diferenciar entre elas com base em suas propriedades metabólicas.
Preparação do Ágar Cled
- Suspenda 36 gramas do meio ágar Cled em um litro de água destilada.
- Misture bem e aqueça com agitação frequente e ferva por um minuto até completar a dissolução.
- Autoclave a 121°C por 15 minutos.
- Arrefecer a 50°C, misturar bem e distribuir em pratos. Quando o meio estiver solidificado, inverta as placas para evitar excesso de umidade. O meio preparado deve ser armazenado a 8-15°C.
Usos do Ágar Cled
- O Ágar Cled é usado para cultura de urina de rotina e usos para crescimento e enumeração de organismos do trato urinário.
- Ajuda na diferenciação de fermentador de lactose e não fermentador de lactose.
- É adequado para o isolamento e contagem de muitos microrganismos de crescimento aeróbico, como Enterobacteriaceae, Pseudomonas e outros bastonetes Gram negativos não fermentadores, enterococos, estafilococos, espécies de Candida e muitos outros de amostras de urina.
Limitações do Ágar Cled
- Estreptococos e outros organismos que necessitam de sangue ou soro para crescimento podem ser recuperados apenas de forma insuficiente neste meio ou podem necessitar de incubação prolongada. Portanto, a amostra também deve ser cultivada em uma placa de ágar sangue se tais organismos forem esperados.
- Patógenos geniturinários como Neisseria gonorrhoeae , Gardnerella vaginalis , Chlamydia , Ureaplasma ou outros organismos exigentes não crescem neste meio.
- Testes sorológicos usando culturas puras são necessários para a identificação completa.
Conclusão sobre Cled Ágar
Concluindo, o ágar Cled é um meio de cultura amplamente utilizado em microbiologia para a detecção e contagem de bactérias presentes em amostras clínicas. Sua composição permite que diferentes tipos de micro-organismos cresçam de forma diferenciada, facilitando a identificação e análise bacteriana.
Precisando de Ágar cled? Entre em contato com nossa equipe.
AVISO DE DIREITOS AUTORAIS: Todo o material deste blog, sendo proibida toda e qualquer forma de plágio, cópia, reprodução ou qualquer outra forma de uso.
Qualquer dúvida técnica sobre os equipamentos contidos no portfólio SPLABOR, entre em contato com o Departamento de Vendas (sp@splabor.com.br)

A Splabor é uma empresa líder no ramo de fabricação de equipamentos para laboratório, especializada em oferecer uma ampla variedade de equipamentos para laboratórios, materiais e produtos para laboratório de alta qualidade.